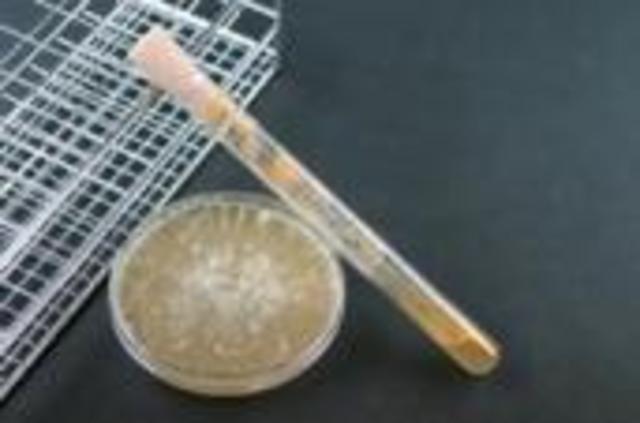
George Beadle and Edward Tatum

-
He transferred pollen from a white flower to a purple flower and then the pollinated carpel turned into a pod. He planted the seeds from the pod and always knew the outcome of the plants. He founded the principle of segregation and the principle of independent assortment.
-
They crossed two doubly heterozygous plants that showed dominant traits. The results did not match the predicted 9:3:3:1 ratio of a dyhybrid cross. This was their discovery of linked genes.
-
He studied fruitflys patterns of inheritance by breeding white eyed flies with red eyed flies. He found that only males had white eyes so he knew that gene was on the sex chromosome. He discovered crossing over, and how to map genes by using recombination frequency.
-
He studied the recurrence patterns of alkaptonuria in several families, and realized that it followed an autosomal recessive pattern of inheritance. He suggested that genes dictate phenotypes through enzymes, the proteins that catalyze chemical prosses in cells.
-
He tested harmless bacteria and a lethal bacteria on mice to see if the mice would die. He mixed the lethal with the harmless and found that the mice died. He concluded that something had caused the cells to become deadly. This experiment led to the discovery that DNA controls the cells.
-
They studied strains of mold on bread that were unable to grow. They found that each mutant turned out to lack an enzyme. They fourmulated the one gene- one enzyme hypothesis. This stated that the function of an individual gene is to dictate the production of a specific enzyme.
-
He used paper chromatography and ultraviolet spectrophotometer for his findings. He came up with the rule that the amount of adenine in DNA was equal to the amount of thymine, and that the amount of guanine was equal to the amount of cytosine.
-
Hershey injected radio active protein into bacteria and found that the radio activity was in the liquid, not the pellet. Chase injected radioactive DNA into bacteria and found that radio activity was in the pellet, not the liquid. This demonstrated that DNA is the genetic material of a bacteriaphage called T2.
-
They took x-ray crystallographic photographs. They produced an x-ray crystallographic photo of DNA and were able to conclude that DNA was a helix.
-
They studied protein structure with x-ray crystallography and said from the photo that the helix had a diameter of 2nm. They tried to construct a double helix using wire models of the nucleotides. They concluded that DNA is a double helix, and that A pairs with T, and G pairs with C.
-
He added one radioactivity labeled amino acid and 19 unlabled amino acids to the extract and discovered the genetic code for phenylalaine. He broke the genetic code and described how it operates in protein synthesis.
Looking for a timeline maker?
Create timelines for projects, roadmaps, history, lessons, legal cases, and stories with Timetoast. Timetoast is a timeline maker for work, school, research, and stories.